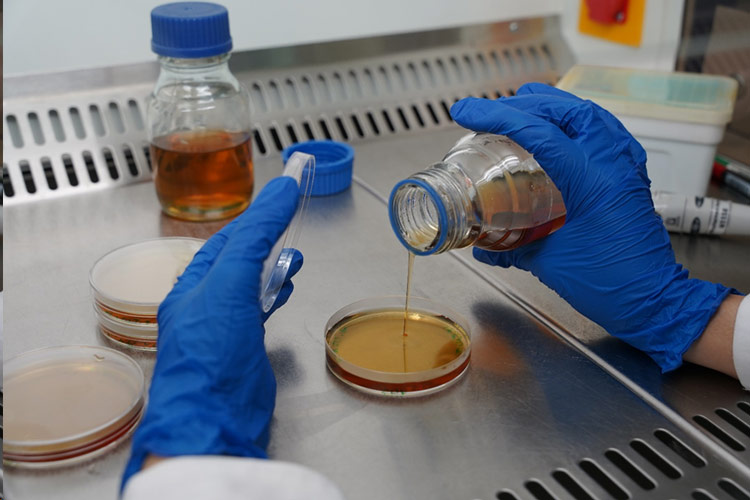
محیط کشت پایه

مجله نیکوسیلز

مقالات
اتاق تمیز چیست
اتاق تمیز یا کلین روم Clean Room یکی از مهمترین زیرساخت ها در صنایع پیشرفته محسوب میشود؛ محیطی کاملا کنترل
بهمن 11, 1404
بدون دیدگاه

مقالات
ضدعفونی کنندههای آزمایشگاه
شناخت ضد عفونی کننده های آزمایشگاه در محیطهای آزمایشگاهی، به ویژه در علوم پزشکی، شیمی، بیولوژی و میکروبیولوژی به دلیل
بهمن 5, 1404
بدون دیدگاه
مقالات
محیط کشت پایه
محیط کشت پایه (Basal Culture Media) ساده ترین و بنیادی ترین نوع محیط کشت در میکروبیولوژی است که برای رشد
بهمن 4, 1404
بدون دیدگاه

مقالات
ظروف پلاستیکی آزمایشگاهی
ظروف پلاستیکی آزمایشگاهی یکی از پرکاربردترین ابزارها در آزمایشگاهها هستند که برای نگهداری، مخلوط کردن و انتقال مواد مختلف به
دی 21, 1404
بدون دیدگاه

مقالات
محیط کشت مایع
محیط کشت مایع چیست؟ محیط کشت مایع که در به انگلیسی Liquid Culture Mediaیا Broth گفته میشود، محیط کشتی است
دی 17, 1404
بدون دیدگاه

مقالات
کشت سلول چیست؟
کِشت سلولی (Cell Culture) یعنی رشد و تکثیر سلولهای زنده یوکاریوتی (انسانی، حیوانی یا گیاهی) در یک محیط مصنوعی و
دی 7, 1404
بدون دیدگاه